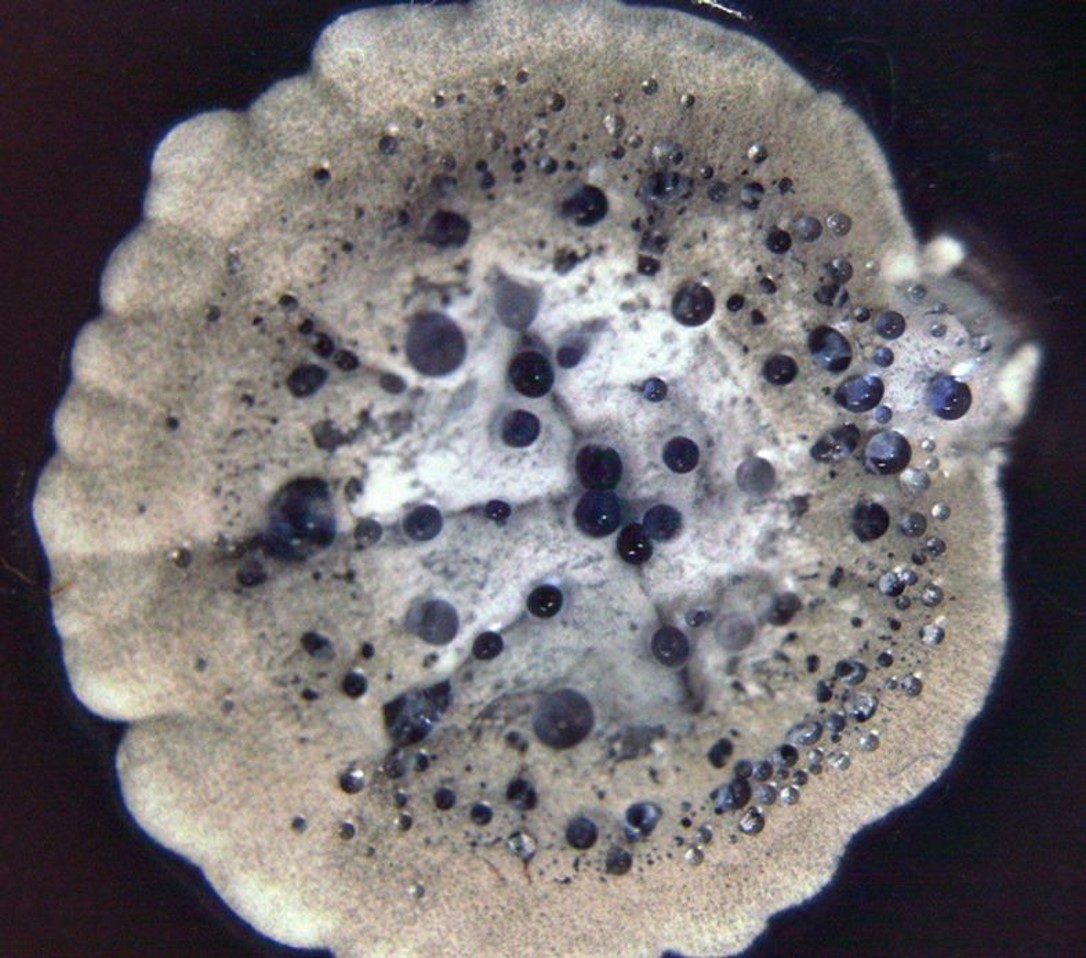
Streptomyces coelicolor enlarged. (Gilles van Wezel)

Het MARBLES-project heeft als doel nieuwe methoden te ontwikkelen voor het duurzaam verzamelen en gebruiken van biologische hulpbronnen uit mariene ecosystemen, en hun commerciële potentieel te evalueren. Samen willen we het onontdekte potentieel van mariene microben benutten als producenten van nieuwe antimicrobiële middelen en als biologische beschermers in de aquacultuur en landbouw, door middel van een integrale, op ecologie-gebaseerde strategie voor het zoeken naar nieuwe natuurstoffen. MARBLES richt zich op de uitdagingen bij het vinden en identificeren van bacteriën en moleculen die ze produceren, het op een duurzaam en effectieve manier extraheren van hun werkzame stoffen, en de commerciële en wettelijke uitdagingen bij het op de markt brengen van ontdekkingen uit het laboratorium.
Duurzame ontdekkingenuit de natuur
Het mariene ecosysteem is grotendeels een onontdekte bron van bron van natuurstoffen met potentie voor toepassingen in de farmaceutische en voedingsindustrie. De grootste uitdagingen liggen onder meer bij het vinden en identificeren van de bacteriën en hun geproduceerde stoffen, het extraheren van de werkzame stoffen op een duurzame en effectieve manier, en commerciële en wettelijke moeilijkheden bij het op de markt brengen van ontdekkingen uit het laboratorium. In het kader van een groeiende wereldbevolking en de huidige klimaat- en biodiversiteitscrises is er een dringende behoefte om duurzaam nieuwe natuurstoffen met farmaceutische en voedingskundige toepassingen te benutten.
Een zeeaan mogelijkheden

De doelstellingen van MARBLES zijn het ontdekken van microben voor gebruik als biologische beschermers in de aquacultuur en landbouw, het ontwikkelen van moleculen en microbiële consortia voor duurzaam commercieel gebruik, het ontdekken van microbiële stoffen met antischimmel- of antimicrobiële activiteit, het ontdekken van stoffen met potentieel voor menselijke gezondheidstoepassingen, het ontdekken van signalen die de expressie van DNA stimuleren voor het verbeteren van screening voor mogelijke nieuwe stoffen, en het verstrekken van op advies voor beleidsdiscussies met betrekking tot biotechnologie gebaseerd op wetenschap.
Door middel van deze doelstellingen zet MARBLES zich in voor de ondersteuning van duurzame ontdekkingen uit de natuur, het ontwikkelen van duurzame methoden voor de exploitatie hiervan samen met de ontwikkeling van natuurlijke milieuvriendelijke producten als alternatief voor milieuschadelijke chemicaliën en medicijnen waarbij de druk op wilde populaties verminderd wordt. Daarnaast streeft MARBLES naar vergroten van de samenwerking tussen de publieke en private sectoren in de biotechnologie en het vergroten van de kennis van het publiek over de potentie van biodiversiteit. Gedurende het hele proces wordt de milieu- en economische duurzaamheid gewaarborgd.
Tot slot
MARBLES streeft ernaar de potentie van de mariene ecosystemen te benutten om nieuwe natuurstoffen met toepassingen in de farmaceutische en voedingsindustrie te ontdekken op een duurzame manier en daarmee milieuvriendelijke alternatieven voor milieubelastende chemicaliën en medicijnen te bieden.

MARBLES maakt deel uit van het AIMS cluster ovan vier onderzoeksprojecten die gefinancierd worden onder de oproep ‘FNR-11-2020: Prospecting aquatics and terrestrial natural biological resources for biologically active compounds.’
De vier cluster projecten zijn Algae4IBD, InnCoCells, MARBLES en SECRETed (AIMS).
Het MARBLES-project heeft financiering ontvangen van het onderzoeks- en innovatieprogramma Horizon 2020 van de Europese Unie onder subsidieovereenkomst nr. 101000392 (MARBLES). Het resultaat weerspiegelt alleen de mening van de auteur en de the ‘European Research Executive Agency (REA)’ kan niet verantwoordelijk worden gehouden voor het gebruik dat ervan kan worden gemaakt.

Werken aanMARBLES
Koos Biesmeijer
Partnersvan MARBLES
MARBLES heeft een interdisciplinair multinationaal consortium van 14 partners uit 10 Europese landen.
- Universiteit Leiden (Nederland)
- ERINN Innovation Ltd (Ierland)
- SINTEF AS (Noorwegen)
- Wageningen University (Nederland)
- University of Aberdeen (Verenigd Koninkrijk)
- University College Cork (Ierland)
- Naicons SRL (Italië)
- Danmarks Tekniske Universiteit (Denemarken)
- Naturalis Biodiversity Center (Nederland)
- Eidegenoessische Technische Hochschule Zuerichethz (Zwitserland)
- Fundacion Centro de Excellencia en Investiacion de Medicamentos Innovadores en Andalucia - MEDINA (Spanje)
- Fraunhofer Gesellschaft zur Foerderung der Angewandten Forschung E.V. (Duitsland)
- European Infrastructure of Open Screening Platforms for Chemical Biology European Research Infrastructure Consortium - EU OPENSCREEN ERIC (Duitsland)
- ABS International (België)
Het project wordt gecoördineerd door de Universiteit Leiden in Nederland.


MeerInformatie
We hebben twee gepubliceerde persberichten:
- New EU project launched to harness the power of marine microbes and their bioactive molecules
- New interactive microscopy exhibition set for Micro Day in Leiden
Project resultaten (inclusief wetenschappelijke publicaties, data, openbare deliverables binnenkort beschikbaar): Resultaten pagina
Blijf op de hoogtie via onze MARBLES nieuws pagina
Project evenementen pagina
Project bronnen pagina (project promotiemateriaal, publieke activiteiten): MARBLES bronnen pagina